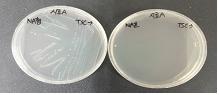

1. 클로스트리디움 퍼프린젠스 [Clostridium perfringens] 란?
내열성 포자를 생성하는 클로스트리디움 퍼프린젠스는 그람양성 간균으로 혐기성균으로 산소가 없는 곳에서 잘 자라는 세균입니다. 특히, 3~5월 기간인 봄철에 많이 발생하는 것으로 알려져 있습니다. 이 균의 특징은 내열성 포자가 있어, 가열 조리한 후 장시간 실온에 방치하면 포자가 다시 생장한다는 점입니다.
따라서, 단체급식소(학교,병원,회사)에서 대량으로 음식을 조리한 후 상온에 장시간 보관했다가 음식을 섭취하게 되면 감염위험이 높아지기 때문에 병원성균을 미리 예방하는 것이 중요합니다.
2. 어떤 식품군이 클로스트리디움 퍼프린젠스 관리대상 식품군은 무엇이 있을까?
|
대상 식품 |
규 격 |
|
① 가)의 대상식품 중 햄류, 소시지류, 식육추출가공품, 알가공품 |
n=5, c=1, m=10, M=100 |
|
② 가)의 대상식품 중 생햄, 발효소시지, 자연치즈, 가공치즈 |
n=5, c=2, m=10, M=100 |
|
③ 가)의 대상식품 중 장류(메주 제외), 젓갈류, 고춧가루 또는 실고추, 향신료가공품, 김치류, 절임류, 조림류, 복합조미식품, 식초, 카레분 및 카레(액상제품 제외) |
n=5, c=2, m=100, M=1,000 (멸균제품은 n=5, c=0, m=0/25g) |
|
④ 위 ①, ②, ③ 을 제외한 가)의 대상식품 |
n=5, c=0, m=0/25g |
3. 클로스트리디움 퍼프린젠스 [Clostridium perfringens] 시험법
클로스트리디움 퍼프린젠스의 시험방법은 크게 정성시험법과 정량시험법으로 나뉩니다.
3.-1. 클로스트리디움 퍼프린젠스 [Clostridium perfringens] 정성시험법
Ⅰ. 시험용액 조제
검체 25g 또는 25mL를 취하여 225mL의 희석액을 가한 후 1~2분간 저속으로 균질화한 후 10배 단계 희석액을 만든다.
Ⅱ. 증균배양
Cooked meat 배지의 아랫부분에 시험용액(시료) 1mL를 접종하여 35~37℃에서 18~24시간동안 혐기배양한다.
이때 검체를 가하지 아니한 동일 희석액 1mL을 대조시험액으로 하여 시험조작의 무균여부를 확인한다.
Ⅲ. 분리배양
난황첨가 TSC에 증균배양액을 접종하여 35~37℃에서 18~24시간동안 혐기배양한다.
불투명한 환을 가지고 중심이 검정색 또는 투명한 집락을 띄는 전형적인 균은 확인시험을 진행한다.
Ⅳ. 확인시험
1) 전형적인 집락을 보통한천배지에 옮겨 35~37℃에서 18~24시간동안 혐기배양한 후 그람염색을 실시한다.
동시에 보통한천배지를 35~37℃에서 18~24시간동안 호기배양하여 균의 비발육을 확인한다.
2) 그람염색을 통해 그람양성 간균임을 확인한다.
3) 보통한천배지의 균을 GAM배지로 접종시켜 35~37℃에서 18~24시간동안 혐기배양 후 운동성의 유무를 파악한다.
4) VITEK 2 동정장비 또는 API KIT를 이용하여 최종 동정을 실시한다.
|
|
|
|
|
|
|
증균배양 |
분리배양 |
1) 확인시험 |
2) 확인시험 |
3) 확인시험 |
3.-2. 클로스트리디움 퍼프린젠스 [Clostridium perfringens] 정량시험법
Ⅰ. 시험용액 조제
검체 25g 또는 25mL를 취하여 225mL의 희석액을 가한 후 1~2분간 저속으로 균질화한 후 10배 단계 희석액을 만든다.
Ⅱ. 균수 측정
시험용액 및 단계별 희석액 1 mL씩을 2매 이상의 멸균 페트리접시에 무균적으로 분주하고, 43~45℃로 유지한
난황을 첨가하지 않은 TSC 한천배지 10~15mL를 가하여 좌우로 돌리면서 잘 혼합한 후 응고시킨다.
응고된 배지 위 동일한 배지 10mL를 가하여 중첩시킨 후 35~37℃에서 18~24 시간 혐기 배양 후 150개 이하의 전
형적인 검은색 집락이 확인된 평판을 선별하여 각 집락의 수를 계수한다.
이때 검체를 가하지 아니한 동일 희석액 1mL을 대조시험액으로 하여 시험조작의 무균여부를 확인한다.
Ⅲ. 확인시험
계수한 평판에서 5개 이상의 전형적인 집락을 선별하여 확인시험을 진행한다.
1) 전형적인 집락을 보통한천배지에 옮겨 35~37℃에서 18~24시간동안 혐기배양한 후 그람염색을 실시한다.
동시에 보통한천배지를 35~37℃에서 18~24시간동안 호기배양하여 균의 비발육을 확인한다.
2) 그람염색을 통해 그람양성 간균임을 확인한다.
3) 보통한천배지의 균을 GAM배지로 접종시켜 35~37℃에서 18~24시간동안 혐기배양 후 운동성의 유무를 파악한다.
4) VITEK 2 동정장비 또는 API KIT를 이용하여 최종 동정을 실시한다.
|
|
|
|
|
|
균수 측정 |
1) 확인시험 |
2) 확인시험 |
3) 확인시험 |
이상으로 클로스트리디움 퍼프린젠스 시험법에 대해 안내드렸습니다. 이외에 문의사항이 있으시면 아래의 연락처로 문의 부탁드립니다.
정다운 주임연구원 : 02-6191-6126